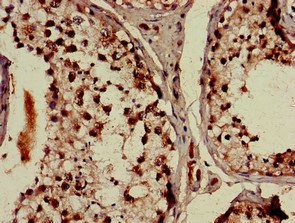

DDX4 Antibody
-
中文名稱:DDX4兔多克隆抗體
-
貨號:CSB-PA882074LA01HU
-
規格:¥440
-
圖片:
-
Immunohistochemistry of paraffin-embedded human cervical cancer using CSB-PA882074LA01HU at dilution of 1:100
-
Immunohistochemistry of paraffin-embedded human testis tissue using CSB-PA882074LA01HU at dilution of 1:100
-
Immunofluorescent analysis of HepG2 cells using CSB-PA882074LA01HU at dilution of 1:100 and Alexa Fluor 488-congugated AffiniPure Goat Anti-Rabbit IgG(H+L)
-
-
其他:
產品詳情
-
產品名稱:Rabbit anti-Homo sapiens (Human) DDX4 Polyclonal antibody
-
Uniprot No.:
-
基因名:
-
別名:DDX 4 antibody; Ddx4 antibody; DDX4_HUMAN antibody; DEAD (Asp Glu Ala Asp) box polypeptide 4 antibody; DEAD box protein 4 antibody; DEAD/H (Asp-Glu-Ala-Asp/His) box polypeptide 4 antibody; MVH antibody; Probable ATP dependent RNA helicase DDX4 antibody; Probable ATP-dependent RNA helicase DDX4 antibody; VASA antibody; Vasa homolog antibody
-
宿主:Rabbit
-
反應種屬:Human
-
免疫原:Recombinant Human Probable ATP-dependent RNA helicase DDX4 protein (1-223AA)
-
免疫原種屬:Homo sapiens (Human)
-
標記方式:Non-conjugated
本頁面中的產品,DDX4 Antibody (CSB-PA882074LA01HU),的標記方式是Non-conjugated。對于DDX4 Antibody,我們還提供其他標記。見下表:
-
克隆類型:Polyclonal
-
抗體亞型:IgG
-
純化方式:>95%, Protein G purified
-
濃度:It differs from different batches. Please contact us to confirm it.
-
保存緩沖液:Preservative: 0.03% Proclin 300
Constituents: 50% Glycerol, 0.01M PBS, pH 7.4 -
產品提供形式:Liquid
-
應用范圍:ELISA, IHC, IF
-
推薦稀釋比:
Application Recommended Dilution IHC 1:20-1:200 IF 1:50-1:200 -
Protocols:
-
儲存條件:Upon receipt, store at -20°C or -80°C. Avoid repeated freeze.
-
貨期:Basically, we can dispatch the products out in 1-3 working days after receiving your orders. Delivery time maybe differs from different purchasing way or location, please kindly consult your local distributors for specific delivery time.
-
用途:For Research Use Only. Not for use in diagnostic or therapeutic procedures.
相關產品
靶點詳情
-
功能:ATP-dependent RNA helicase required during spermatogenesis. Required to repress transposable elements and preventing their mobilization, which is essential for the germline integrity. Acts via the piRNA metabolic process, which mediates the repression of transposable elements during meiosis by forming complexes composed of piRNAs and Piwi proteins and governs the methylation and subsequent repression of transposons. Involved in the secondary piRNAs metabolic process, the production of piRNAs in fetal male germ cells through a ping-pong amplification cycle. Required for PIWIL2 slicing-triggered piRNA biogenesis: helicase activity enables utilization of one of the slice cleavage fragments generated by PIWIL2 and processing these pre-piRNAs into piRNAs.
-
基因功能參考文獻:
- Four sterility-related genes, including BOLL, DDX4, HORMAD1, and MAEL, were found to have increased methylation at CpGs of the promoter regions and decreased mRNA expressions in nonobstructive azoospermia and hypospermatogenesis (HS) testis and are believed to be associated with HS. PMID: 28342926
- positivity for DDX4 gene was detected in 17 of 39 males with nonobstructive azoospermia which was due to maturation arrest in 35.3% of cases, due to incomplete Sertoli cell only in 23.5% and due to complete Sertoli cell only in 41.2%. PMID: 28000927
- Results suggest that DDX4 positively regulates cell cycle progression of diverse somatic-derived blood cancer cells, implying its broad contributions to the cancer cell phenotype. PMID: 28612512
- DDX4 cell-free seminal mRNA was absent in 44% of Sertoli cell-only syndrome cases diagnosed by testicular histopathology, but present in all patients presenting with maturation arrest or hypospermatogenesis PMID: 27211570
- The 20-mer peptide (residues 228-247) of human DDX-4, an ATP-dependent RNA helicase known to regulate germ cell development, binds to a unique shallow binding surface on RanBPM formed by highly conserved loops on the surface of the beta-sheet with two aspartates on one end, a positive patch on the opposite end, and a tryptophan lining at the bottom of the surface. PMID: 27622290
- Data show that intrinsically disordered N terminus of DEAD-box RNA helicase Ddx4 forms organelles in HeLa cells and in vitro. PMID: 25747659
- this study reports the first analysis and comparison of the expression patterns and colocalization of DDX4 and CD133 in 59 ovarian cancer patients via tissue microarray and immunofluorescence analysis to identify the expression patterns and relationship of those two markers in ovarian cancer cells. PMID: 24727449
- Data suggest that VASA shows differential expression in ovary; in resting primordial follicle reserve in childhood/pre-puberty, VASA is associated with Balbiani's body space in germ cell; once follicle enters growing pool, VASA is undetectable. PMID: 23315064
- Vasa/Ddx4 gene can be involved in regulation of ground and primed states of pluripotency PMID: 22288104
- overexpression of VASA and or DAZL, in both embryonic and induced pluripotent stem cells promoted differentiation into primordial germ cells, and maturation and progression through meiosis was enhanced. PMID: 22162380
- Report the generation/characterization of embryonic stem cell lines carrying a VASA-pEGFP-1 reporter construct that expresses GFP in a population of differentiating cells showing expression of characteristic markers of primordial germ cells. PMID: 19937754
- marker for normal and malignant germ cells PMID: 11850529
- The expression of VASA mRNA and protein was significantly decreased in the sperm of oligozoospermic men. PMID: 17486274
- VASA showed a differential pattern of expression throughout the differentiation and proliferative phase and prophase I to finally associate with Balbiani's body in primordial and primary follicles. PMID: 18534994
- Over-expression of VASA abrogates the G2 checkpoint, induced by DNA damage, by down-regulating the expression of 14-3-3sigma. Results suggest that VASA may play a role in the progression of ovarian cancer or serve as a valuable marker of tumorigenesis. PMID: 18805576
- Highly methylated regions of the VASA gene are associated with maturation arrest phenotype in the testis. PMID: 19629140
顯示更多
收起更多
-
亞細胞定位:Cytoplasm. Cytoplasm, perinuclear region.
-
蛋白家族:DEAD box helicase family, DDX4/VASA subfamily
-
組織特異性:Expressed only in ovary and testis. Expressed in migratory primordial germ cells in the region of the gonadal ridge in both sexes.
-
數據庫鏈接:
Most popular with customers
-
-
YWHAB Recombinant Monoclonal Antibody
Applications: ELISA, WB, IHC, IF, FC
Species Reactivity: Human, Mouse, Rat
-
Phospho-YAP1 (S127) Recombinant Monoclonal Antibody
Applications: ELISA, WB, IHC
Species Reactivity: Human
-
-
-
-
-
VDAC1 Recombinant Monoclonal Antibody
Applications: ELISA, WB, IHC
Species Reactivity: Human, Mouse, Rat